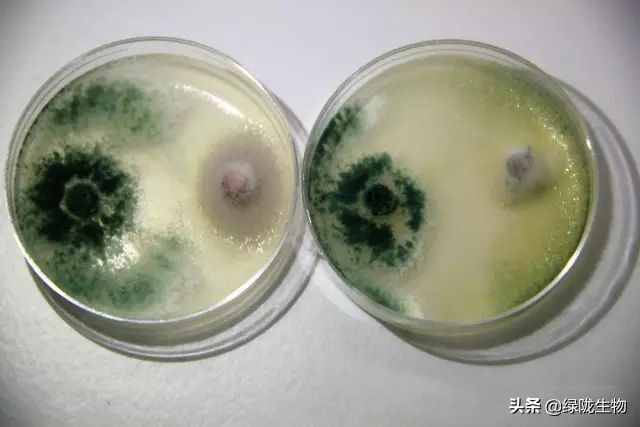
木霉如何防治,木霉菌防治什么病害

木霉菌作用机制
1、产生抗生素
木霉菌可以产生挥发性或非挥发性抑制病原菌生长的抗生物质,如三柯胜、三柯得茗、粘帚毒素、煤尼毒素及胜肽素等。
司齐博克(Mary Schirmbock)等人曾观察到哈氏木霉菌可产生细胞壁分解酵素及胜肽博素的抗生素,如果把这种抗生素与几丁质分解酵素结合,可抑制病原菌孢子发芽与菌丝生长。

2、营养竞争
利用竞争能力强的微生物,消耗如铁、氮、碳、氧或其它适宜病原菌生长的微量元素,可以限制病原菌的生长、发芽或代谢。在这方面,木霉菌主要是夺取或阻断病原菌所需的养分。
由于营养竞争很难用变异菌株加以证明,而且添加物质也可能会改变病害的发生,以致无法取得强而有力的证据,显示防治的机制是与竞争养分有关。
目前较具明证者,仅在铁、铜等离子的竞争方面,而这又与能否产生嵌合物质等具有相关性,因为这类物质也会减少病原菌的发芽与生长。
3、细胞壁分解酵素

一般认为细胞壁分解酵素在抑制病害上 扮演着 重要的角色。
由于几丁质与葡聚糖是真菌细胞壁的主要成分(除卵菌纲外),很多试验显示几丁质分解酵素或葡聚糖分解酵素,单独或组合使用时可直接分解真菌细胞壁。近来遗传学上也证明,缺乏几丁质分解酵素的突变菌株,其抑制病原菌孢子发芽的能力以及病害防治能力都明显降低。
4、微寄生
以木霉菌的微寄生立枯丝核病菌为例,其过程大约可分成四个步骤。
首先是趋化性生长,也就是木霉菌会趋向能产生化学刺激物的病原菌生长。
第二个步骤是辨识,这个步骤和病原菌含有的聚血素及拮抗菌表面拥有的碳水化合物接收器有关,这类物质左右了病原菌与拮抗微生物之间作用的专一性。
第三个步骤是接触与细胞壁分解。最后则是穿刺作用,也就是木霉菌会产生类似附着器的构造,侵入真菌细胞,进而分解与利用病原菌细胞物质。

5、诱导植物产生抗性
植物的系统性诱导抗病现象,是指植物经第一次接种原或非生物因子刺激后,产生对第二次接种原的抗性。
这种抗性的发展,可导致植株对多种病原的感染都会有抵抗性,而非仅限于对原先的诱导病原。
目前已有报告显示,植物经木霉菌处理后,可诱导产生特别的酵素等物质,进而对叶部病害或病毒病害产生抗性